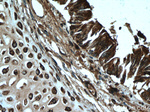
NOSIP Antibody in Immunohistochemistry (Paraffin) (IHC (P))

Search
Proteintech
NOSIP Polyclonal Antibody
{{$productOrderCtrl.translations['antibody.pdp.commerceCard.promotion.promotions']}}
{{$productOrderCtrl.translations['antibody.pdp.commerceCard.promotion.viewpromo']}}
{{$productOrderCtrl.translations['antibody.pdp.commerceCard.promotion.promocode']}}: {{promo.promoCode}} {{promo.promoTitle}} {{promo.promoDescription}}. {{$productOrderCtrl.translations['antibody.pdp.commerceCard.promotion.learnmore']}}
产品信息
27979-1-AP
种属反应
宿主/亚型
分类
类型
抗原
偶联物
形式
浓度
规格
纯化类型
保存液
内含物
保存条件
运输条件
产品详细信息
Immunogen sequence: MTRHGKNCT AGAVYTYHEK KKDTAASGYG TQNIRLSRDA VKDFDCCCLS LQPCHDPVVT PDGYLYEREA ILEYILHQKK EIARQMKAYE KQRGTRREEQ KELQRAASQD HVRGFLEKES AIVSRPLNPF TAKALSGTSP DDVQPGPSVG PPSKDKDKVL PSFWIPSLTP EAKATKLEKP SRTVTCPMSG KPLRMSDLTP VHFTPLDSSV DRVGLITRSE RYVCAVTRDS LSNATPCAVL RPSGAVVTLE CVEKLIRKDM VDPVTGDKLT DRDIIVLQRG GTGFAGSGVK LQAEKSRPVM QA (1-301 aa encoded by BC010077)
靶标信息
NEDD4L is an E3 ubiquitin-protein ligase which accepts ubiquitin from an E2 ubiquitin-conjugating enzyme in the form of a thioester and then directly transfers the ubiquitin to targeted substrates. NEDD4L inhibits TGF-beta signaling by triggering SMAD2 and TGFR1 ubiquitination and proteasome-dependent degradation. NEDD4L promotes ubiquitination and internalization of various plasma membrane channels such as ENaC, Nav1. 2, Nav1. 3, Nav1. 5, Nav1. 7, Nav1. 8, Kv1. 3, EAAT1 or CLC5. NEDD4L also promotes ubiquitination and degradation of SGK.
仅用于科研。不用于诊断过程。未经明确授权不得转售。
篇参考文献 (0)
生物信息学
蛋白别名: E3 ubiquitin-protein ligase NOSIP; eNOS-interacting protein; Nitric oxide synthase-interacting protein; RING-type E3 ubiquitin transferase NOSIP; unnamed protein product
基因别名: CGI-25; NOSIP
UniProt ID: (Human) Q9Y314
Entrez Gene ID: (Human) 51070